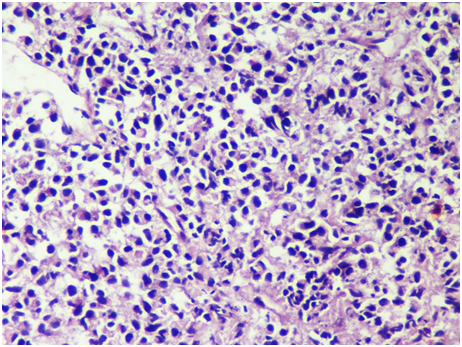

eISSN: 2471-0016


Case Report Volume 6 Issue 3
1Department of Pathology, KUSMS, Dhulikhel Hospital, Nepal
1Department of Pathology, KUSMS, Dhulikhel Hospital, Nepal
2Department of Anesthesiology and critical care, Bhaktapur cancer Hospital, Nepal
2Department of Anesthesiology and critical care, Bhaktapur cancer Hospital, Nepal
Correspondence: Sujita Bhandari, Kathmandu University of medical sciences, Dhulikhel Hospital, KUSMS, Dhulikhel Hospital, kavre, Nepal, Tel 9845585285
Received: January 01, 1971 | Published: May 7, 2018
Citation: Bhandari S, Makaju R, Baral SR. Solitary plasmacytoma of rib: a rare presentation. Int Clin Pathol J. 2018;6(3):130–132. DOI: 10.15406/icpjl.2018.06.00172
Solitary Plasmacytoma of Bone (SPB)is a rare neoplasm that accounts for about 5% of all plasma cell neoplasms. Clinically, it presents as a localized lytic bone lesion. Its diagnosis is based on identification of localized monoclonal plasma cells with immunohistochemistry.SPB commonly involves spine and pelvis while the involvement of rib is very rare with only a few sporadic cases reported before. We report this case of solitary plasmacytoma of left 5th and 6th ribs in a 43‒year‒old male. It was clinically and radiologically diagnosed as sarcoma. Histopathological examination and immunohistochemistry enabled the diagnosis of plasmacytoma. Further biochemical investigations, bone marrow examination and radiological assessment were performed to fulfill the diagnostic criteria of solitary plasmacytoma of bone.
Keywords: chest wall, plasmacytoma, ribs, Solitary tumor
Plasmacytoma is a localized collection of neoplastic plasma cells presenting either as a solitary lesion or a manifestation of multiple myeloma.1 The International Myeloma Working Group has defined a diagnostic criteria for Solitary Plasmacytoma of Bone which requires all the following to be fulfilled: (i) biopsy‒proven solitary lesion of bone or soft tissue with evidence of clonal plasma cells, (ii) Normal bone marrow with no evidence of clonal plasma cells, (iii) Normal skeletal survey and MRI (or CT) of the spine and pelvis (except for the primary solitary lesion), and (iv) Absence of end‒organ damage such as hypercalcemia, renal insufficiency, anemia, or bone lesions (CRAB) that can be attributed to a lymphoplasma cell proliferative disorder.2
The SPB is a rare neoplasm that accounts for only 5% of all plasma cell neoplasms.3 It manifests as a lytic bone lesion that commonly occurs in spinal column and, with decreasing frequency, in pelvis, ribs, upper extremities, skull and sternum. SPB has better prognosis than that of multiple myeloma with a median survival of 7 to 9yrs.4
A 43years old male presented with the complaint of gradual onset of swelling in left lateral chest wall since 3 months which was preceded by trauma at his work. Swelling was associated with mild grade of pain. On examination, there was an approximately 9x4cms sized swelling fixed to the chest wall but free from the overlying skin (Figure 1). CECT scan of the chest showed soft tissue density mass causing osteolytic destruction of 5th and 6th ribs interiorly with the possible diagnosis of a sarcoma.
Fine needle aspiration cytology was performed which showed singly scattered monotonous population of atypical cells with high nuclear to cytoplasmic ratio. Few populations of cells revealed the bi‒nucleated forms with eccentrically placed nucleus, prominent nucleoli and basophilic cytoplasm (Figure 2). With mere cytology, it was difficult to give a definitive diagnosis so it was labelled as a small round blue cell tumor (SRBCT) with the differential diagnoses of Non‒Hodgkin’s Lymphoma, Plasma Cell neoplasm, Osteosarcoma and poorly differentiated metastatic carcinoma. Biopsy was advised for further evaluation. Tru‒cut biopsy showed diffuse sheet of monotonous population of dark blue round cells, few with eccentrically placed nucleus and eosinophilic cytoplasm. Bi‒nucleated forms were seen. This morphology was similar to cytomorphologic study done before (Figure 3). Further workups with hematologic studies, biochemical investigations and immunohistochemistry were performed to settle the diagnostic dilemma.

Figure 2 Pap Stain, Fine needle aspiration cytology showing atypical singly scattered cells with eccentrically placed nucleus (400x).
Figure 3H & E Section shows atypical small round blue cells in diffuse sheets, some with eccentrically placed nucleus and eosinophilic cytoplasm HPE (400X).
Complete hemogram with bone marrow aspiration (BMA) and trephine biopsy (BMB) examination were performed. Hemogram showed total leucocyte count of 8x103 cumm with normal range of differential leucocyte count and hemoglobin of 13.4gm/ml. Bone marrow study was normocellular for age with normal myeloid to erythroid ratio and milligram of less than 5% of plasma cells. Biochemical parameters were studied to rule out end organ damages. Renal function test were normal in range with creatinine level of 0.9. Serum calcium level was 9.2mg/dl with albumin 4g/l. Serum electrophoresis revealed prominent M‒spike in gamma fraction. Urine for Bence‒Jones protein was negative.
Immunohistochemistry (IHC) showed diffuse grade 3+ expression of CD138 (Figure 4) and it was immunonegative for pancytokeratin, (Figure 5) vimentin and CD45 (Figure 6). With the immunohistochemistry studies, lymphoma, epithelial tumor and mesenchymal tumor were excluded. IHC for restricted kappa and lambda light chain was not available.
X‒ray reported no evidence of other lytic bone lesions and whole body bone scan showed abnormally increased uptake of radioisotope in the left 5th rib with no other foci in the body. Cumulating all the diagnostic parameters, the patient fulfilled the diagnostic criteria of solitary plasmacytoma of bone originating in the rib. The patient was then referred to oncology center where he was treated by radiotherapy which was followed by surgery. He has excellent disease control and is currently under follow‒up.
Localized solitary plasmacytoma of bone is a rare disease and is characterised by only one or two isolated bone lesions with no evidence of disease dissemination.SPB is defined as a biopsy‒proven solitary lesion of bone or soft tissue with evidence of clonal plasma cells. It has been classified into two types: (1) osseous and (2) non‒osseous primary lesions. Thoracic spine is the most common site for SPB while the upper respiratory tract is the most common location for extramedullary lesions. The incidence of SPB has been reported to be approximately 3/10 00 000 annually in US.4 Men are affected twice as often as women with male to female ratio of 1.3:1 and mean age at diagnosis is 55‒65 yrs.5,6 Although there is also evidence that younger people can be affected if preceding trauma.7 One observational study shows influence of race and plasmacytomas, and found that Whites had intermediate risk comparing to Black (higher risk) and Asians, although this result was not statistically significant and more studies would be necessary to make considerations about this relationship.8
SPB commonly presents as an expansible lytic mass localized within the axial skeleton. Chest wall swelling is rare presenting sign of solitary plasmacytoma. Tumor develops along spinal column with decreasing frequency in pelvis, ribs, upper extremities, face, skull, femur and sternum.4 Whitney Pasch reviewed the cases of SPB in young individuals. He reported 6 cases involving vertebrae, while 3 patients had tibial lesions and 2 patients had rib lesions.7 Thoracic vertebrae are more commonly involved than lumbar or cervical vertebrae. Thus, severe back pain or spinal cord compression or a pathological fracture may be the presenting complaint.
In chest wall, Primary bone tumors followed by mesenchymal malignant tumors and metastatic tumors are common rather than solitary plasmacytoma. Sabanathan et al.,9 studied 53 primary rib tumors in 1984, reported 26 benign and 27 malignant tumors. Among them, chondroma was the commonest benign tumor (42.3%) followed by osteochondroma, osteoblastoma and fibrous dyplasia while chondrosarcoma (48.1%) was the commonest malignant primary chest wall tumor followed by osteosarcoma, Ewing sarcoma and lastly plasmacytoma (15.1%).9
The course of treatment has been discussed over the last decades, with consensus of local radiotherapy as first line option. The chance of recurrence can occur in up to 5‒10% of patients after the treatment. Reported in most series, 10‒year survival is about 50%, being 25‒40% of patients disease free at that time. There are chances of transformation of SPB to multiple myeloma. Transformation is higher with SPB than extramedullary plasmacytoma. Study showed that 35–85% of SPB cases were transformed to multiple myeloma within months to a few years.10
SBP is rare tumor presenting in a rare site, their diagnosis can be challenging to expert. Clinical presentation can often mislead on the pursuit of the correct diagnosis. CECT scan and percutaneous needle biopsy are best investigations to diagnose chest lesions. SBP usually presents with lytic bone lesion. So plasmacytoma should always be kept in mind for differential diagnosis of a bony lytic lesion in rib. The diagnosis is based on identification of the localized tumor composed of monoclonal plasma cells identical to those observed in multiple myeloma, and absence of the signs of a disseminated form.
We would like thank our patient for providing detail information and being cooperative.
The author declares that there is none of the conflicts.

©2018 Bhandari, et al. This is an open access article distributed under the terms of the, which permits unrestricted use, distribution, and build upon your work non-commercially.